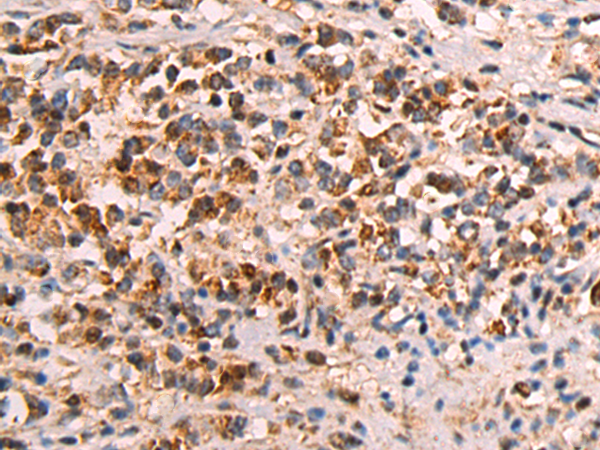

技術(shù)規(guī)格
Background:
The protein encoded by this gene is a member of the keratin family. The keratins are intermediate filament proteins responsible for the structural integrity of epithelial cells and are subdivided into cytokeratins and hair keratins. The type I cytokeratins consist of acidic proteins which are arranged in pairs of heterotypic keratin chains. The type I cytokeratin genes are clustered in a region of chromosome 17q12-q21. Alternative splicing results in multiple transcript variants.
Applications:
ELISA, WB, IHC
Name of antibody:
KRT23
Immunogen:
Fusion protein of human KRT23
Full name:
keratin 23
Synonyms:
K23; CK23; HAIK1
SwissProt:
Q9C075
ELISA Recommended dilution:
5000-10000
IHC positive control:
Human gastric cancer and Human tonsil
IHC Recommend dilution:
50-200
WB Predicted band size:
48 kDa
WB Positive control:
Hela cell lysate
WB Recommended dilution:
500-2000

購物車
幫助
021-54845833/15800441009
